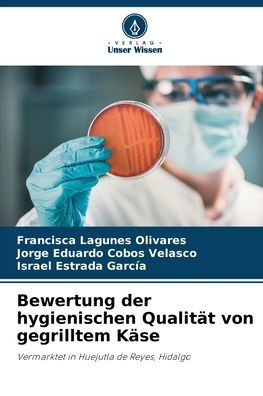
Bewertung der hygienischen Qualitï¿½t von gegrilltem Kï¿½se

Home
Bewertung der Degradation von Weideland in Afar
Barnes and Noble
Loading Inventory...
Bewertung der Degradation von Weideland in Afar in Franklin, TN
Current price: $59.00

Barnes and Noble
Bewertung der Degradation von Weideland in Afar in Franklin, TN
Current price: $59.00
Loading Inventory...
Size: OS
Dieses Buch ist für alle gedacht, die mehr über die Wahrnehmung der Bevölkerung hinsichtlich der Degradation von Weideland, deren Ursachen und Folgen in Weidegebieten sowie in der Bevölkerung selbst erfahren möchten, kombiniert mit wissenschaftlichen Erkenntnissen: Boden, Vegetationsbedeckung und Landnutzung/Landbedeckungsänderungen insgesamt und speziell in Afar, Äthiopien. Es ist auch eine nützliche Einführung für Studierende der Tier- und Weidewissenschaften.
Dieses Buch ist für alle gedacht, die mehr über die Wahrnehmung der Bevölkerung hinsichtlich der Degradation von Weideland, deren Ursachen und Folgen in Weidegebieten sowie in der Bevölkerung selbst erfahren möchten, kombiniert mit wissenschaftlichen Erkenntnissen: Boden, Vegetationsbedeckung und Landnutzung/Landbedeckungsänderungen insgesamt und speziell in Afar, Äthiopien. Es ist auch eine nützliche Einführung für Studierende der Tier- und Weidewissenschaften.